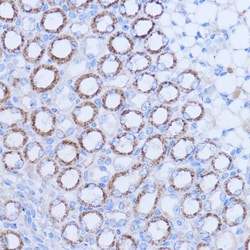
Invitrogen MT-ND1 Polyclonal Antibody 100 &mu;L; Unconjugated:Antibodies,

Promotional price valid on web orders only. Your contract pricing may differ. Interested in signing up for a dedicated account number?
Learn More
Learn More
Invitrogen™ MT-ND1 Polyclonal Antibody


Rabbit Polyclonal Antibody
Supplier: Invitrogen™ PA5120599
This item is not returnable.
View return policy
Description
Positive test controls include: HeLa, HepG2, 293T, mouse heart, mouse brain, mouse kidney, rat heart, rat brain. Immunogen sequence: MPMANLLLLI VPILIAMAFL MLTERKILGY MQLRKGPNVV GPYGLLQPFA DAMKLFTKEP LKPATSTITL YITAPTLALT IALLLWTPLP MPNPLVNLNL.
A small number of complex I subunits are the products of mitochondrial genes (subunits 1-7), while the remainder are nuclear encoded and imported from the cytoplasm. NADH dehydrogenase subunit 1 (ND1) binds rotenone and rotenone analogs and might be involved in electron transfer to ubiquinone. Mutations in the ND1 gene may be implicated in several disorders, including Leber hereditary optic neuropathy, Alzheimer's disease and Parkinson disease.
Specifications
| MT-ND1 | |
| Polyclonal | |
| Unconjugated | |
| mt-Nd1 | |
| mitochondrially encoded NADH dehydrogenase 1; Mtnd1; MT-ND1; NADH dehydrogenase; NADH dehydrogenase subunit 1; NADH1; NADH-ubiquinone oxidoreductase chain 1; Nd1 | |
| Rabbit | |
| Affinity Chromatography | |
| RUO | |
| 17716, 26193, 4535 | |
| -20°C, Avoid Freeze/Thaw Cycles | |
| Liquid |
| ELISA, Immunohistochemistry (Paraffin), Western Blot, Immunocytochemistry | |
| 2.05 mg/mL | |
| PBS with 50% glycerol and 0.09% sodium azide; pH 7.3 | |
| P03886, P03888, P03889 | |
| mt-Nd1 | |
| Synthetic peptide. | |
| 100 μL | |
| Primary | |
| Human, Mouse, Rat | |
| Antibody | |
| IgG |
Product Content Correction
Your input is important to us. Please complete this form to provide feedback related to the content on this product.
Product Title
Spot an opportunity for improvement?Share a Content Correction